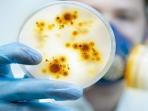
Tak Disangka 19 Barang yang Ada di Rumah Ini Ternyata Menyimpan Ratusan Hingga Puluhan Ribu Bakteri Penyebab Penyakit

Properti
Properti - Blog TribunJualBeli.com
3 Ide Desain Interior untuk Millenial yang Baru Punya Rumah
1 Desember 2019
Cari Hunian? Ini Pilihan Rumah Daerah Yogyakarta, Siap di Huni
13 November 2019
Nih 7 Inspirasi Ruang Tamu yang Instagramable, Kece Banget
3 November 2019
Intip 7 Desain Rumah Paling Enggak Masuk Akal
27 Oktober 2019
Intip 3 Desain Unik Toilet Umum yang Ada di Dunia
15 Oktober 2019
3 Penyebab Lampu di Rumah Cepat Putus atau Rusak
28 September 2019
Artikel Populer
- Dijual Tanah Luas 3.7 Ha SHM Kawasan Industri dan Pergudangan…
- Dijual Rumah Minimalis Tipe 36 1KT 1KM SHM - Sleman
- Dijual Gudang Showroom Jalan Sultan Agung Medan Satria - Bekasi
- Dijual Rumah Baru Modern Minimalis Tipe 106 Boulevard Hijau…
- Jual Rumah Tipe 60 dengan Tanah 167m2 Cuma 400 Jutaan di Prambanan…